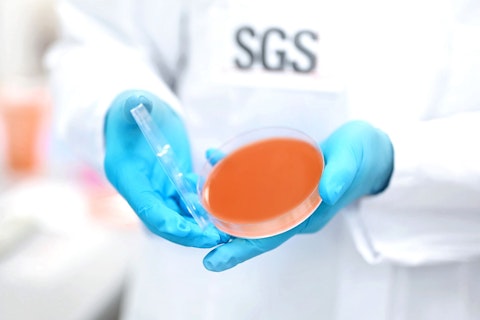
SGS Microbiology Services Lab Hamburg, Germany

Publication Date
38 results found

Shining a Light on UV Filter Analysis
Learn how expert UV filter analysis supports safer cosmetics, validated claims and stronger regulatory compliance.
Read more
Expanded Accredited Microbiological Testing Capabilities in France
Expanded ISO/IEC 17025 accreditation at Plouzané laboratory strengthens microbiological testing, supporting compliance, safety and market access across pharmaceuticals, cosmetics, antiseptics and disinfectants.
Read more
France Publishes Updated PFAS Regulation for Consumer Products
On January 1, 2026, France implemented strict controls on PFAS under Decree No. 2025-1376, published on December 28, 2025.
Read more
Turkey Publishes Import Controls for Toys and other Consumer Goods
Turkey has updated three communiqués on import inspections for toys and other goods.
Read more
Spain Proposes New Accessible Labeling Rules for Cosmetic Products
Understand Spain’s new accessible labeling rules: what they require, who must comply and how to prepare.
Read more
Why Outsourcing Quality Control Makes Sense for Cosmetics
Exploring how outsourced cosmetic quality control boosts compliance, reduces costs and accelerates safe, market-ready product development.
Read more
California Enacts Musk Reduction Act Restricting Cosmetic Ingredients
California Musk Reduction Act bans key cosmetic ingredients from 2027, protecting consumer health and safety.
Read more
Implementing Decision (EU) 2025/1175 of the European Commission – Updated Glossary of Cosmetic Ingredient Names
Implementing Decision (EU) 2025/1175 updates the INCI Glossary used for cosmetic labeling across the EU.
Read more
Launch of ISO 23698: 2024 HDRS – A Breakthrough Sunscreen Testing Method
This new sunscreen testing method is safer, faster and more-cost-effective than existing methods.
Read more
Skin Longevity From Ancient Wisdom to Modern Clinical Evaluation
Explore how non-invasive clinical tools and biomarkers advance skin longevity assessment and substantiate product efficacy.
Read more